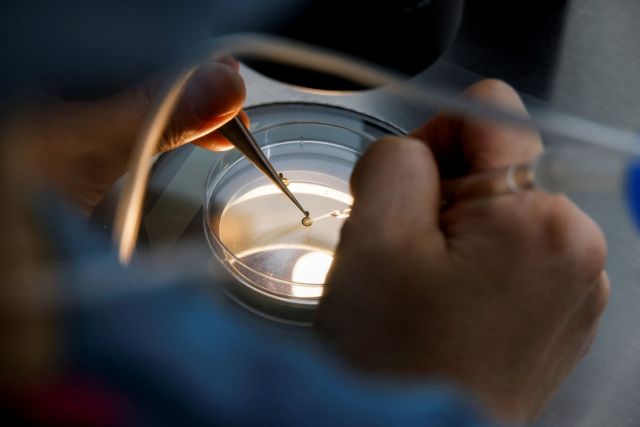
Ευλογιά των πιθήκων: Θα υπάρξει κρούσμα στην Ελλάδα – Τι είπε ο Θάνος Πλεύρης

Στην ευλογιά των πιθήκων αναφέρθηκε σήμερα το πρωί ο υπουργός Υγείας, Θάνος Πλεύρης λέγοντας, μεταξύ άλλων, πως «Η μεταδοτικότητα μέχρι στιγμής με τα δεδομένα που έχουμε είναι μια μεταδοτικότητα σχετικά χαμηλή, γιατί κατά βάση θέλει σωματική επαφή και μεταφέρεται και με τα σταγονίδια μόνο όταν πια έχει εκδηλωθεί. Δηλαδή κατά βάση όταν ο άλλος βλέπει ότι έχει τρομακτικά συμπτώματα. Δεν τίθεται θέμα μαζικού εμβολιασμού, χθες δεν τέθηκε τέτοιο θέμα ούτε σε σύσκεψη που έγινε στον Παγκόσμιο Οργανισμό Υγείας».
«Η χώρα μας θα παραγγείλει μια παρτίδα εμβολίων στο πλαίσιο της Ευρωπαϊκής Επιτροπής. Τα εμβόλια θα αφορούν άτομα που έχουν έρθει σε επαφή με κρούσματα, γιατί τότε αν εμβολιαστείς, μπορείς να το αντιμετωπίσεις πιο εύκολα. Είναι πολύ κοντά και στην προληπτική αντιμετώπιση της ευλογιάς των πιθήκων, εάν εκτεθείς», σημείωσε ο υπ. Υγείας μιλώντας στον Ant1.
Όπως συμπλήρωσε ο κ. Πλεύρης, «έρευνες δείχνουν ότι 1 στους 50 κόλλησε από πολύ στενή επαφή με κρούσμα. Πρέπει να ανησυχούμε, αλλά στον βαθμό που πρέπει. Αν δεν είχε υπάρξει ο κοροναϊός, δεν θα συζητούσαμε τόσο πολύ για την νόσο αυτή».
«Οι άνω των 50 ετών, που έχουν εμβολιαστεί κατά της ευλογιάς, φαίνεται πως έχουν κάποια ανοσία», ανέφερε ο Υπ. Υγείας, ενώ τόνισε πως δεν τίθεται προς ώρας ζήτημα επαναφοράς του εμβολιασμού του γενικού πληθυσμού έναντι της ευλογιάς.
Επεσήμανε πάντως πως «με μαθηματική ακρίβεια θα υπάρξει κρούσμα στην Ελλάδα, θα βρεθεί περιστατικό και στην χώρα μας, αλλά αυτό δεν πρέπει να μας ανησυχήσει».
«Προσωπικός Γιατρός»
Αναφερόμενος στον θεσμό του «Προσωπικού Γιατρού», ο Υπουργός Υγείας είπε πως «δεν θέλουμε έναν γιατρό για συνταγογράφηση. Σήμερα σε μεγάλο βαθμό οι συμβεβλημένοι με τον ΕΟΠΥΥ γιατροί, εξυπηρετούν αυτήν την ανάγκη, για συνταγογράφηση. Εμείς θέλουμε αρχικώς ο προσωπικός γιατρός να έχει πλήρεις φακέλους για κάθε πολίτη και να τον παρακολουθεί».
«Θα είναι υποχρεωμένος ο γιατρός να τον βλέπει τον πολίτη σε τακτικές και έκτακτες επισκέψεις στο ιατρείο του. Για κατ΄ οίκον επίσκεψη του γιατρού, θα πρέπει να συντρέχουν ορισμένοι λόγοι για κατηγορίες πολιτών που δεν μπορούν εύκολα να μετακινηθούν», συμπλήρωσε ο κ. Πλέυρης.
Αποσαφήνισε πως στο πρόγραμμα «μπορεί να συμμετέχουν όλοι οι γενικοί γιατροί κάθε περιοχής, τόσο ιδιώτες όσο και οι γιατροί των Κέντρων Υγείας. Δεν αναγκάζουμε τον πολίτη να πάει στον γενικό γιατρό. Μπορεί να πάει σε ειδικό γιατρό. Ο γενικός γιατρός θα είναι η «επαφή» του ασθενούς με το ΕΣΥ. Για πρώτη φορά δίνουμε την δυνατότητα ένας ειδικός γιατρός, πχ. πνευμονολόγος, καρδιολόγος κτλ. που παρακολουθεί ασθενή για συγκεκριμένο πρόβλημα όπως ΧΑΠ ή καρδιακή νόσο, αυτός να γίνει ο προσωπικός γιατρός του ασθενή».
Ετήσιο εισόδημα έως 60.000 ευρώ για τους γιατρούς
Αν παρακολουθούμε κάθε πολίτη από νωρίς, θα μπορούμε να προλάβουμε εγκαίρως κάποιο πρόβλημα, σημείωσε ο κ. Πλευρης.
Όπως είπε ο υπουργός Υγείας, «ο γιατρός θα μπορεί να έχει ένα ετήσιο εισόδημα έως 60.000 ευρώ, είναι μεγάλο το ποσό, καθώς ο γιατρός θα πληρώνεται ανάλογα με τον αριθμό των ασθενών που εξετάζει. Μιλάμε για μεγάλο ποσό, για μηνιαίο μισθό από 4.000 έως 6.000 το μήνα, γιατί αυτά θα είναι τα ποσά που θα απευθύνονται στον προσωπικό γιατρό, είναι σοβαρά χρήματα γιατί ακριβώς θέλουμε ο γιατρός να αγκαλιάσει το θεσμό, να θελήσει να μπει και να έχουμε και περισσότερες απαιτήσεις από αυτόν, διότι όταν κάποιον τον αμείβεις με αυτά τα χρήματα μπορείς να ζητήσεις την πλήρη δωρεάν περίθαλψη, την οποία θέλουμε να διασφαλίσουμε για τον ασφαλισμένο».